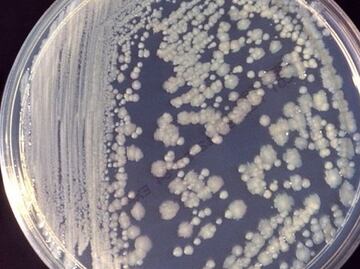
¿Bacterias en el espacio? Sí, también se adaptan para sobrevivir

Más Información

Pensión Mujeres con Bienestar 2025: ¿Cuándo es el último día de registro?; no te quedes sin este apoyo

Nuevos requisitos Infonavit: ¿cuántos puntos se necesitarán para obtener una vivienda?; esto se sabe
Antonio toma cada día el metro para ir al trabajo, se agarra a la barandilla mientras sube las escaleras de la estación. Pulsa el botón del ascensor y abre la puerta de la oficina. Antes de comer baja a la calle para sacar dinero de un cajero automático, con el que paga un bocadillo que se come despreocupadamente sin lavarse las manos.
Si las manos de nuestro imaginario amigo fueran reales, ahora podrían estar cubiertas de bacterias resistentes a antibióticos. Una investigación, cuyos resultados se publican en la revista Scientific Reports , ha encontrado estafilococos (Staphylococcus) multirresistentes en muestras tomadas en lugares públicos de Londres similares a los tocados por Antonio.
“Nuestra investigación subraya el hecho de que las áreas públicas pueden ser reservorios para bacterias multirresistentes ”, explica la investigadora de la Universidad del Este de Londres y coautora del estudio, Hermine Mkrtchyan.
Los autores obtuvieron 600 aislados de estafilococos de sitios como manijas de puertas, botones de ascensores, cajeros automáticos, barandillas, dispensadores de jabón y tapas de retrete. Todos ellos situados en lugares como estaciones de metro, centros comerciales y zonas públicas de hospitales; del este y oeste de Londres.
De estos 600 aislados, casi la mitad (281 colonias, un 46,83 %) eran resistentes a al menos dos antibióticos. Los fármacos que mostraron una mayor resistencia fueron la penicilina (80,42 %), el ácido fusídico (72,4 %) y la eritromicina (54,45 %).
Genes resistentes para diferentes antibióticos
“Encontramos una gran diversidad de genes resistentes para diferentes antibióticos, así como elementos genéticos móviles [capaces de transferirse a otros microorganismos]”, comenta Mkrtchyan.
Uno de ellos fue el gen mecA , presente en 49 de las muestras (8,17 %). Este codifica la proteína PBP2a , con una baja afinidad por los antibióticos betalactámicos. En otras palabras, confiere resistencia a su portado frente al grupo más utilizado de estos fármacos, que incluye la penicilina y la cefalosporina.
Las bacterias resistentes fueron algo más comunes en hospitales que en el resto de zonas (49,5 % frente a 40,66 %) y en el este que en el oeste (56,7 % frente a 49,96 %), algo que los autores atribuyen al mayor uso clínico de estos fármacos y a las diferencias en la densidad de población.
Las especies multirresistentes más comunes fueron S. epidermidis, S. haemolyticus y S. hominis , que suelen formar parte de la microbiota de la piel humana, donde actúan como comensales. La científica explica que, aunque muchas de ellas no suelen ser patógenas, sí son oportunistas. “Normalmente no provocan enfermedades, pero eso puede cambiar si se les da la oportunidad”.
Más peligrosa es la posibilidad de que los genes y elementos de resistencia presentes en estos microorganismos puedan pasar a patógenos humanos. De hecho, un ‘hermano’ de las bacterias analizadas, S. aureus resistente a la meticilina, acabó con la vida de casi 20 mil estadounidenses el año pasado debido a infecciones hospitalarias.
“Aunque [las bacterias analizadas en el estudio] no sean patógenas, el hallazgo de niveles crecientes de resistencia en lugares públicos y hospitales es perturbadora”, añade Mkrtchyan.
Los motivos por los que estos microorganismos resistentes parecen estar tan extendidos por la ciudad no son difíciles de imaginar: “Los estafilococos pueden difundirse por el contacto piel-piel y piel-superficie”.
El siguiente paso para el equipo de Mkrtchyan es llevar a cabo análisis genómicos comparativos para “descifrar” las características genéticas de la multirresistencia a antibióticos en estas muestras de estafilococos. “Queremos entender su origen para evaluar mejor estos aislados”, dice la investigadora.